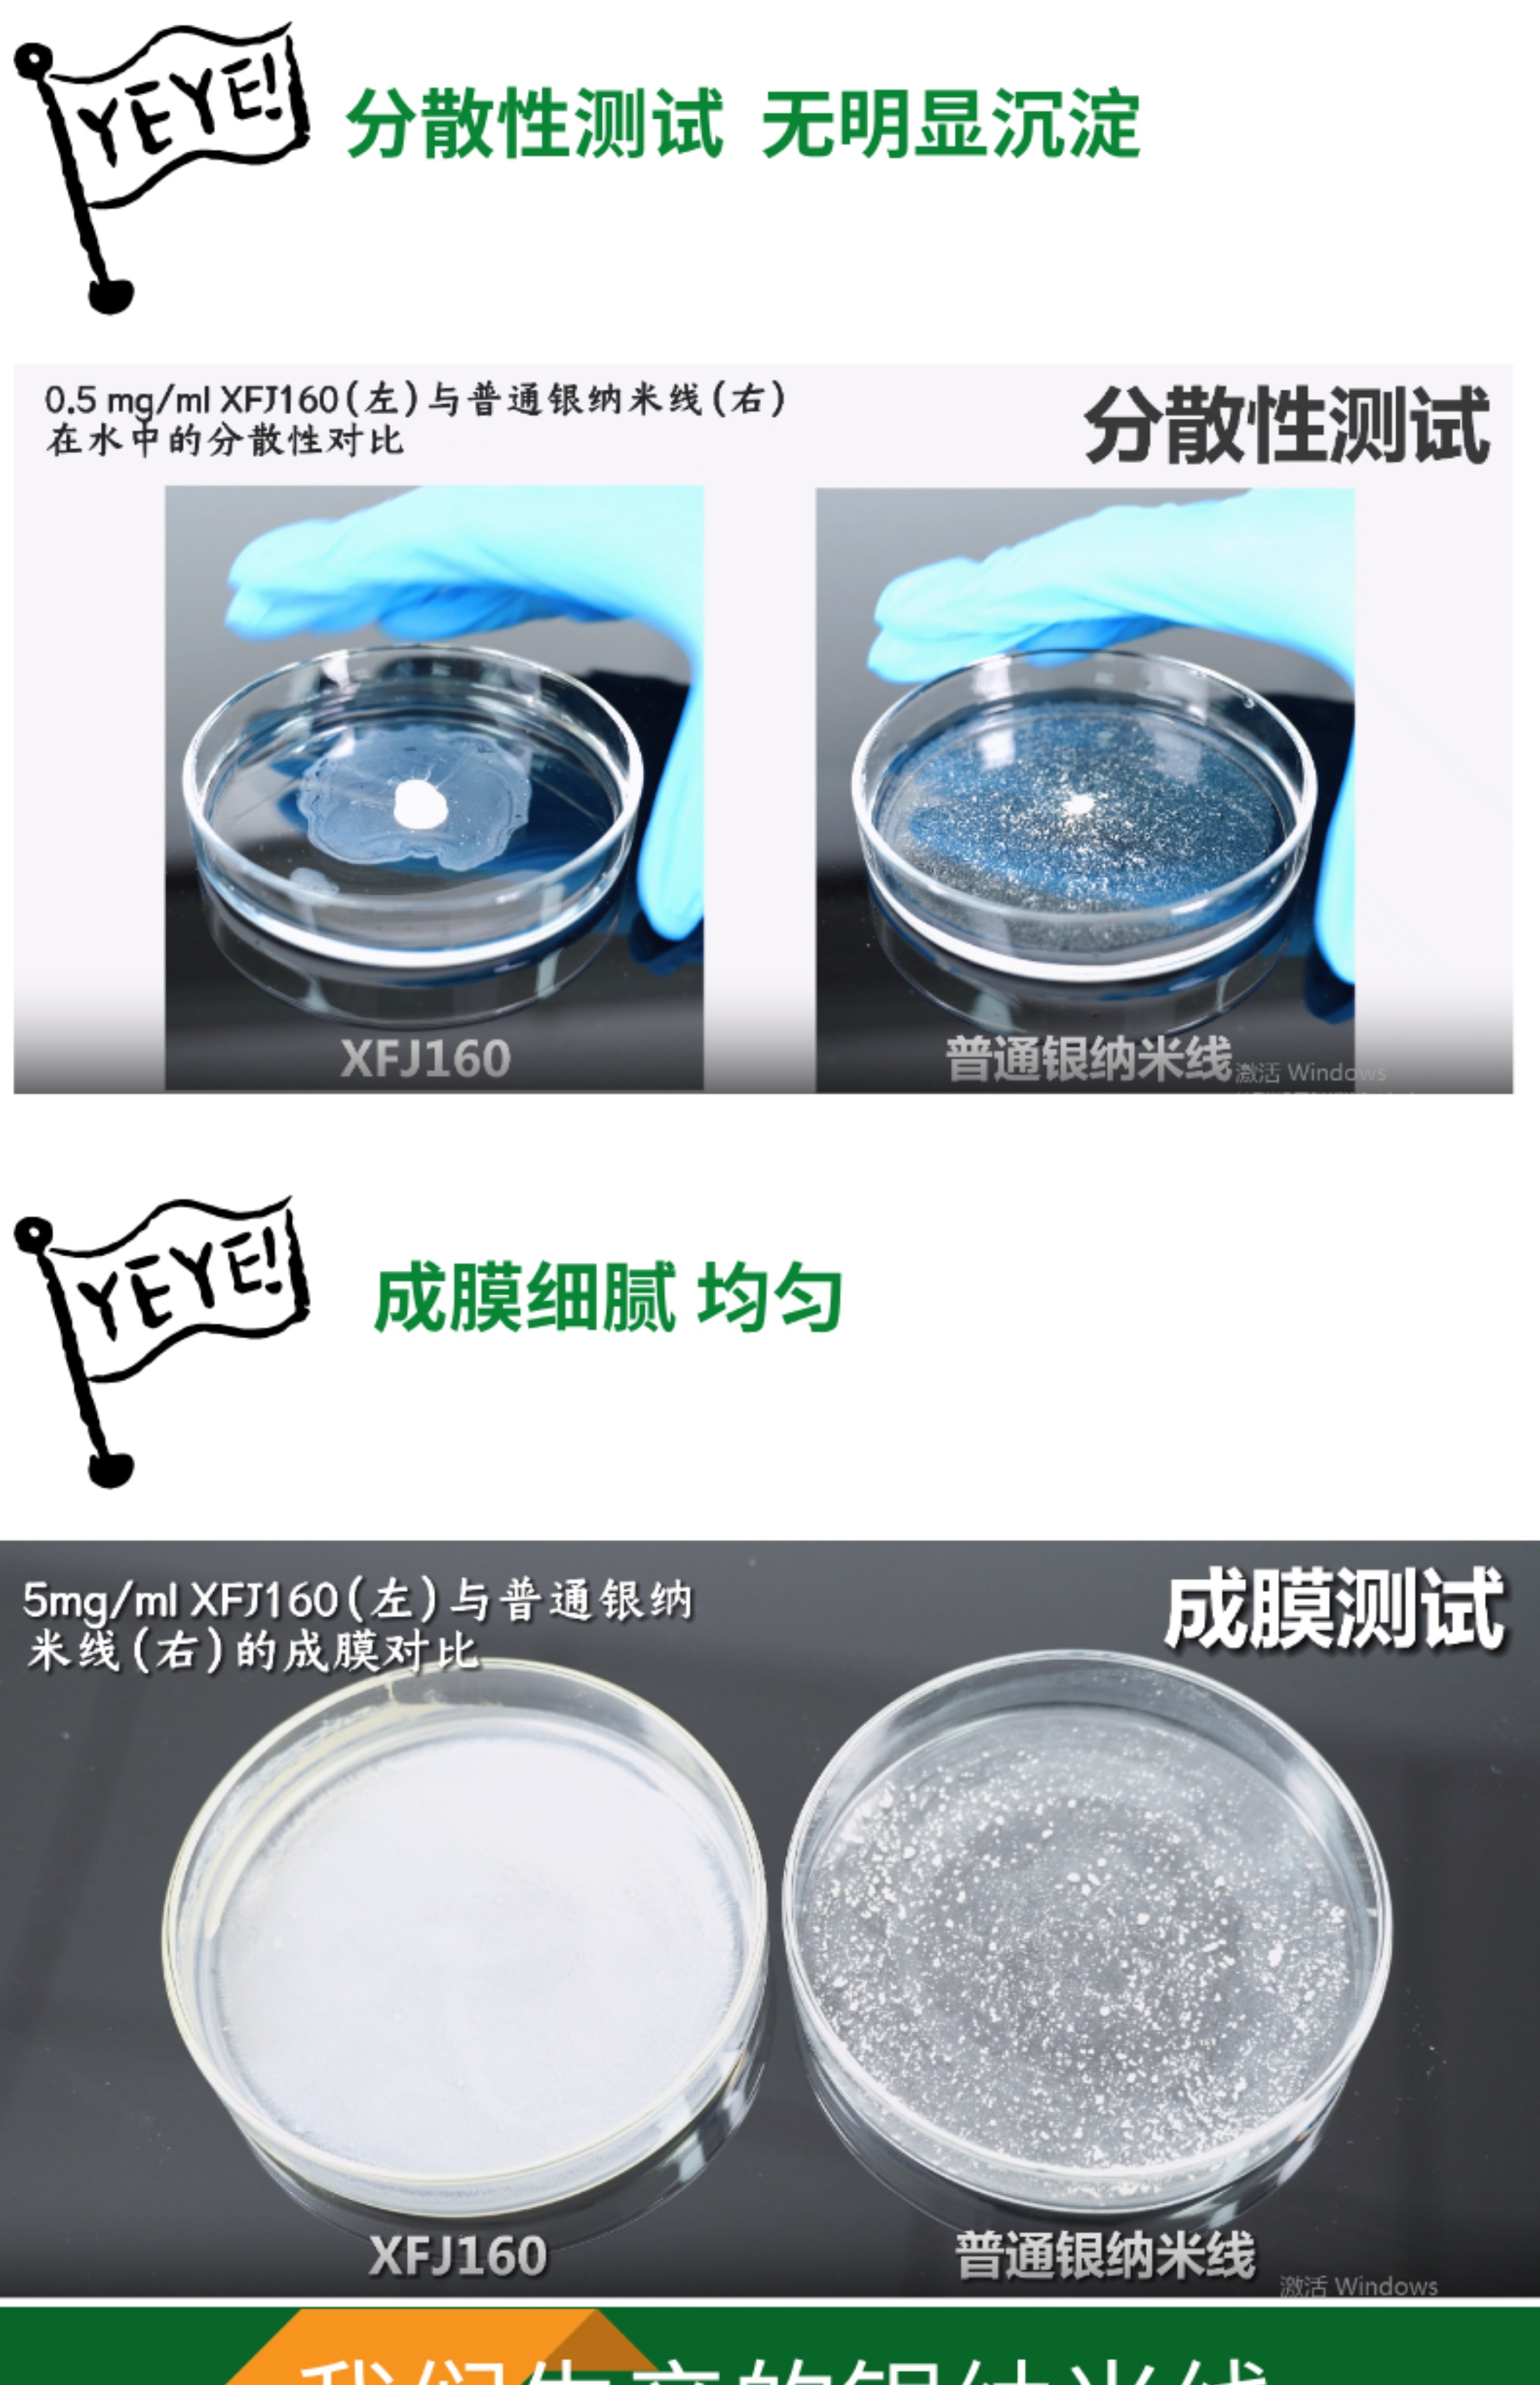

全部19个规格
| 颜色分类 | 售价 | 原价 | 库存 | 重量 | 体积 | 编码 | 条码 | 购买数量 | 操作 |
|---|---|---|---|---|---|---|---|---|---|
| 银纳米线直径100-200nm1g浓度10mg/ml溶剂水 XFJ25 | ¥ 登录可见 | ¥ 登录可见 | 9999 件 | 816478378884 |
|
||||
| 银纳米线直径100-200nm1g浓度10mg/ml溶剂乙醇 XFJ25 | ¥ 登录可见 | ¥ 登录可见 | 9999 件 | 816478378884 |
|
||||
| 银纳米线直径100-200nm1g浓度10mg/ml溶剂甲醇 XFJ25 | ¥ 登录可见 | ¥ 登录可见 | 9999 件 | 816478378884 |
|
||||
| 银纳米线直径100-150nm1g浓度10mg/ml溶剂水 XFJ26 | ¥ 登录可见 | ¥ 登录可见 | 9999 件 | 816478378884 |
|
||||
| 银纳米线直径100-150nm1g浓度10mg/ml溶剂乙醇 XFJ26 | ¥ 登录可见 | ¥ 登录可见 | 9999 件 | 816478378884 |
|
||||
| 银纳米线直径100-150nm1g浓度10mg/ml溶剂甲醇 XFJ26 | ¥ 登录可见 | ¥ 登录可见 | 9999 件 | 816478378884 |
|
||||
| 银纳米线30nm500mg浓度10mg/ml长度20um溶剂水 XFJ95 | ¥ 登录可见 | ¥ 登录可见 | 9999 件 | 816478378884 |
|
||||
| 银纳米线30nm500mg浓度10mg/ml长度20um溶剂乙醇 XFJ95 | ¥ 登录可见 | ¥ 登录可见 | 9999 件 | 816478378884 |
|
||||
| 银纳米线30nm500mg浓度10mg/ml长度20um溶剂异丙醇 XFJ95 | ¥ 登录可见 | ¥ 登录可见 | 9999 件 | 816478378884 |
|
||||
| 银纳米线30nm1g浓度10mg/ml长度20um溶剂水 XFJ95 | ¥ 登录可见 | ¥ 登录可见 | 9999 件 | 816478378884 |
|
||||
| 银纳米线30nm1g浓度10mg/ml长度20um溶剂乙醇 XFJ95 | ¥ 登录可见 | ¥ 登录可见 | 9999 件 | 816478378884 |
|
||||
| 银纳米线30nm1g浓度10mg/ml长度20um溶剂异丙醇 XFJ95 | ¥ 登录可见 | ¥ 登录可见 | 9999 件 | 816478378884 |
|
||||
| 银纳米线30nm250mg浓度10mg/ml长度20um溶剂乙醇 XFJ95 | ¥ 登录可见 | ¥ 登录可见 | 9999 件 | 816478378884 |
|
||||
| 银纳米线30nm250mg浓度5mg/ml长度20um溶剂水 XFJ95 | ¥ 登录可见 | ¥ 登录可见 | 9999 件 | 816478378884 |
|
||||
| 银纳米线30nm250mg浓度5mg/ml长度20um溶剂乙醇 XFJ95 | ¥ 登录可见 | ¥ 登录可见 | 9999 件 | 816478378884 |
|
||||
| 银纳米线30nm250mg浓度5mg/ml长度20um溶剂异丙醇 XFJ95 | ¥ 登录可见 | ¥ 登录可见 | 9999 件 | 816478378884 |
|
||||
| 银纳米线30nm250mg浓度10mg/ml长度20um溶剂异丙醇 XFJ95 | ¥ 登录可见 | ¥ 登录可见 | 9999 件 | 816478378884 |
|
||||
| 银纳米线载盐酸阿霉素制备~10mL浓度5mg/ml XFB51 | ¥ 登录可见 | ¥ 登录可见 | 9999 件 | 816478378884 |
|
||||
| 定制银纳米线价格货期咨询 XFDZSN | ¥ 登录可见 | ¥ 登录可见 | 9999 件 | 816478378884 |
|

没有相关规格
看了又看